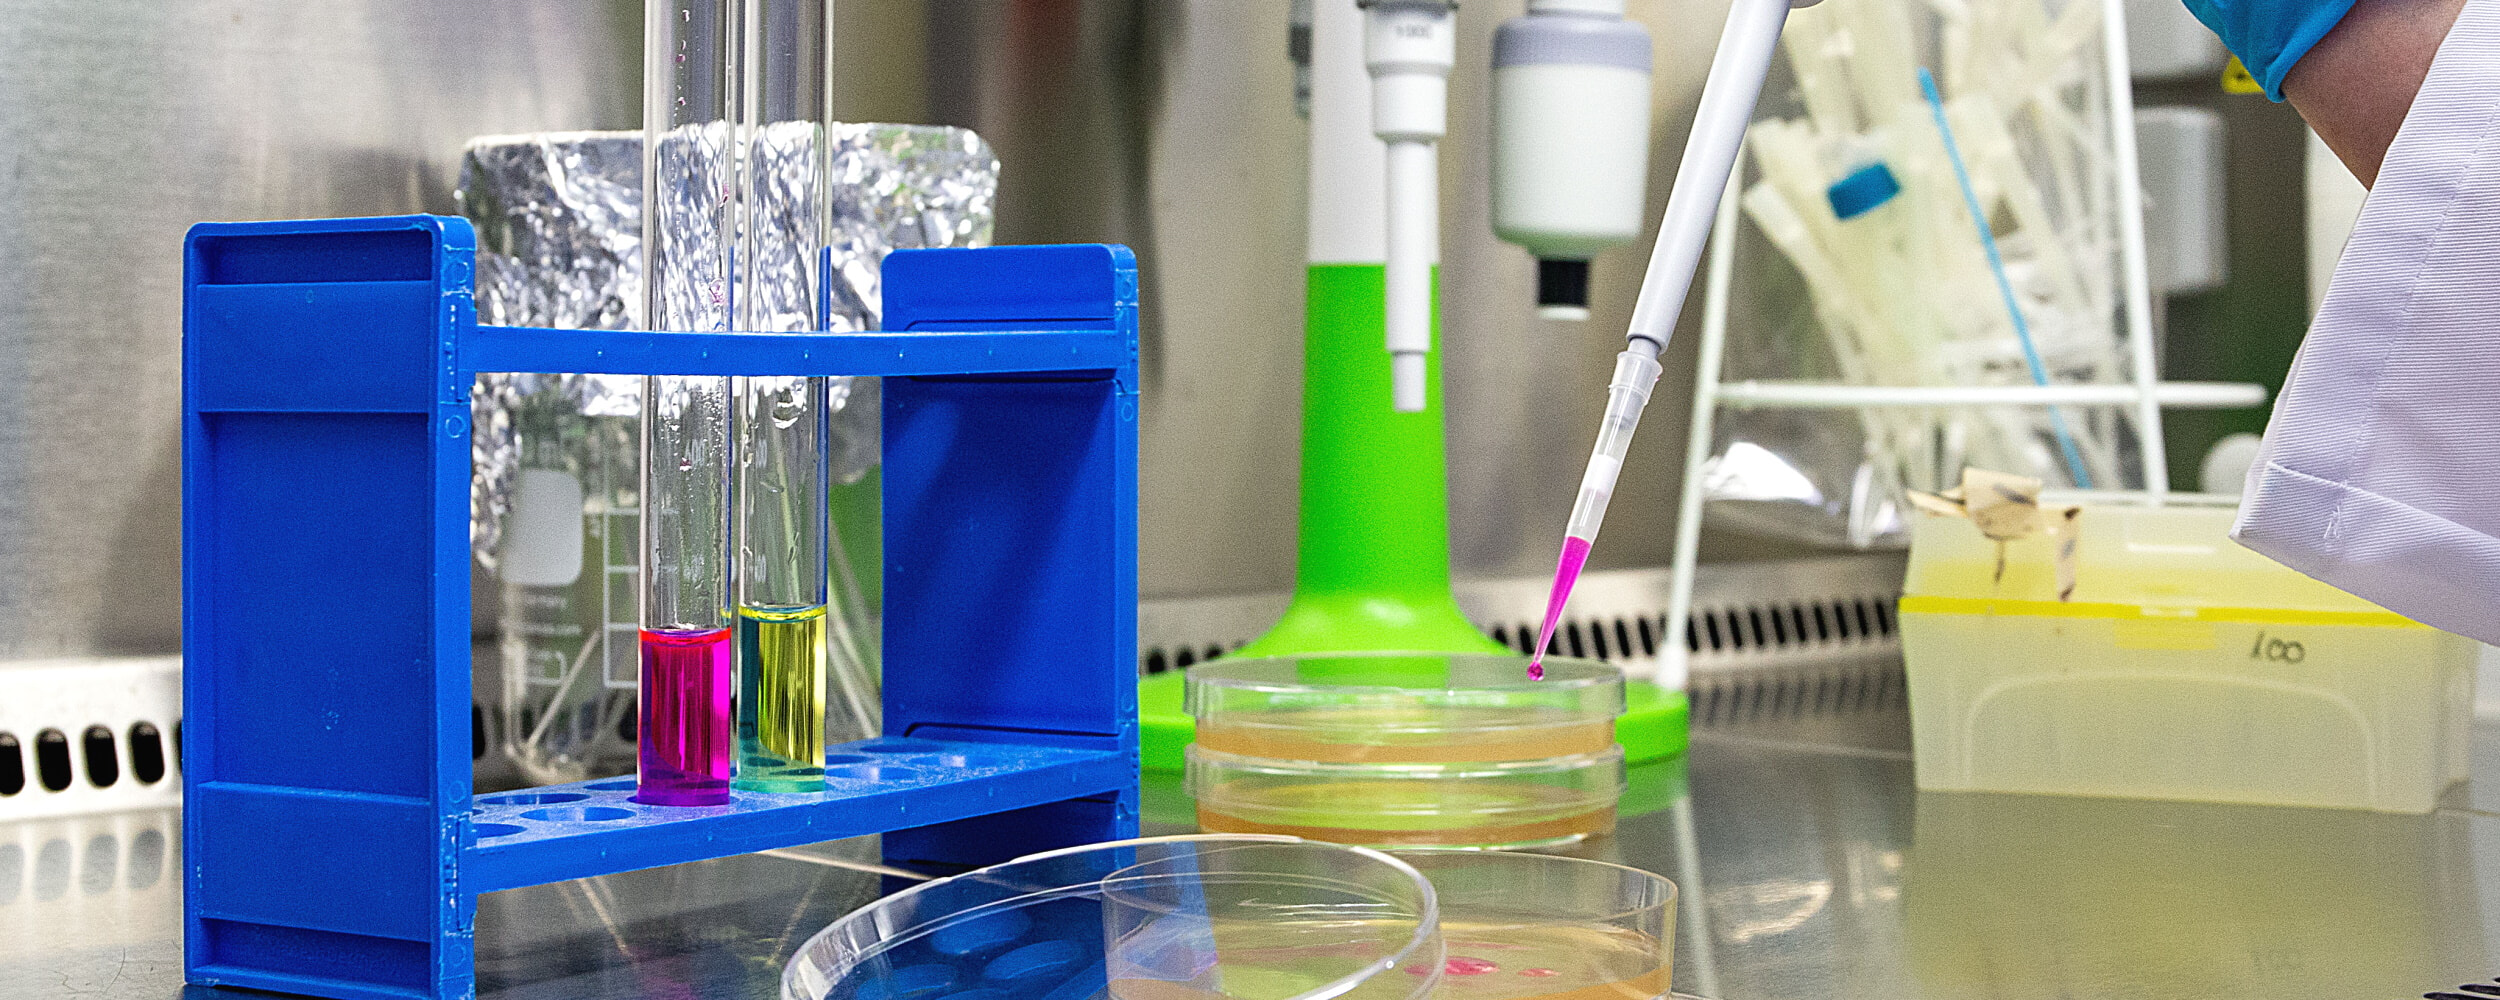

Entwicklung
In unserem hauseigenen Labor entwickeln wir Ihr Private Label Produkt nach Ihren Wünschen.
Der Entwicklungsprozess
Alles beginnt mit Ihrer Idee und Ihrer Kontaktaufnahme zu uns. Mit unserer langjährigen Erfahrung beraten wir Sie gern persönlich. Wir sind während des gesamten Entwicklungsprozesses für Sie da. Einen vereinfachten Überblick zeigt das nachfolgende Schaubild.
Ihre Idee
… ist der Anfang.
Kontaktaufnahme
Sie erzählen uns von Ihrem Vorhaben.
Entwicklung
Unser hauseigenes Labor entwickelt Muster.
Prüfung
Sie erhalten die fertigen Muster zur Prüfung und Freigabe.
Verpackung
Wir besprechen die Verpackungsmöglichkeiten mit Ihnen.
Bestellung
Sie erhalten unser Angebot und können Ihre erste Bestellung platzieren.
Produktion
Wir starten die Materialbeschaffung und beginnen mit der Produktion.
Lieferung
Sie erhalten Ihre erste Lieferung.
Nachhaltige Entwicklung
„So viel wie nötig, so wenig wie möglich“: Nachhaltige Rohstoffe und umweltfreundliche Produkte stehen bei uns im Fokus. Gern unterstützen wir Sie auch bei der ökologischen Zertifizierung Ihres Produktes.